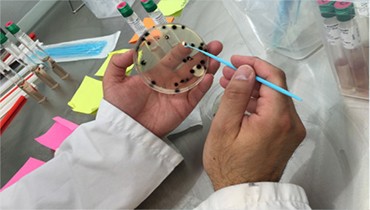
project

Laboratoire Allal el fassi
Depuis 2018, nos patients nous font confiance pour pratiquer leurs examens au sein de notre centre de prélèvement. Nous effectuons ainsi leurs analyses dans plusieurs disciplines : Microbiologie, Biochimie, Hématologie, Hémostase, Immunologie, Hormonologie, Marqueurs tumoraux, Sérologies…
Notre laboratoire est organisé en plateaux techniques équipés de matériels à la pointe de la technologie pour garantir à nos patients les meilleurs délais de réalisations de leurs analyses dans des conditions de qualité optimale.
Et nous investissons chaque année dans la montée en compétence de notre équipe à travers des programmes de formations médicales, gage d’une amélioration continue de nos services.


Laboratoire Allal el fassi
Depuis 2018, nos patients nous font confiance pour pratiquer leurs examens au sein de notre centre de prélèvement. Nous effectuons ainsi leurs analyses dans plusieurs disciplines : Microbiologie, Biochimie, Hématologie, Hémostase, Immunologie, Hormonologie, Marqueurs tumoraux, Sérologies…
Notre laboratoire est organisé en plateaux techniques équipés de matériels à la pointe de la technologie pour garantir à nos patients les meilleurs délais de réalisations de leurs analyses dans des conditions de qualité optimale.
Et nous investissons chaque année dans la montée en compétence de notre équipe à travers des programmes de formations médicales, gage d’une amélioration continue de nos services.